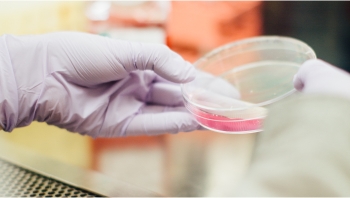

Related guides and insights
We leverage the collective knowledge and experience of our dedicated life sciences sector group across the globe to develop market-leading products and thought-leadership that provide our clients with the intelligence and insight they need to gain competitive advantage.